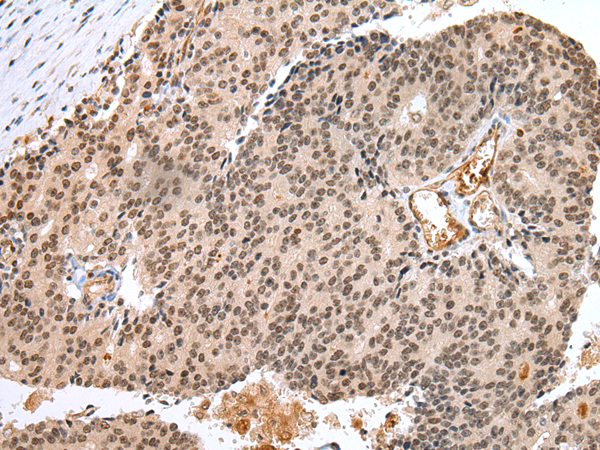

|
Background: |
This gene belongs to subfamily P of the forkhead box (FOX) transcription factor family. Forkhead box transcription factors play important roles in the regulation of tissue- and cell type-specific gene transcription during both development and adulthood. Forkhead box P1 protein contains both DNA-binding- and protein-protein binding-domains. This gene may act as a tumor suppressor as it is lost in several tumor types and maps to a chromosomal region (3p14.1) reported to contain a tumor suppressor gene(s). Alternative splicing results in multiple transcript variants encoding different isoforms. |
|
Applications: |
ELISA, IHC |
|
Name of antibody: |
FOXP1 |
|
Immunogen: |
Synthetic peptide of human FOXP1 |
|
Full name: |
forkhead box P1 |
|
Synonyms: |
MFH; QRF1; 12CC4; hFKH1B; HSPC215 |
|
SwissProt: |
Q9H334 |
|
ELISA Recommended dilution: |
2000-5000 |
|
IHC positive control: |
Human esophagus cancer and Human prostate cancer |
|
IHC Recommend dilution: |
25-100 |
購物車
幫助
021-54845833/15800441009
